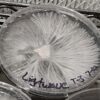

Light wave (Albino A+ x tidal wave)Typically medium-sized with lighter-colored caps that can have wavy or undulating edges; stems are sturdy and white, bruising blue upon handling.
Lightwave (Tidal wave x Albino A+)
Related products
-
Albino makilla gorilla
$19.99 Select options This product has multiple variants. The options may be chosen on the product pageRated 0 out of 5 -
Black °1
$19.99 Select options This product has multiple variants. The options may be chosen on the product pageRated 0 out of 5 -
Enigma
$19.99 Select options This product has multiple variants. The options may be chosen on the product pageRated 0 out of 5 -
Blue Ghost
$19.99 Select options This product has multiple variants. The options may be chosen on the product pageRated 0 out of 5
| Media | Isolated Liquid Syringe, Agar Plate |
|---|
Be the first to review “Lightwave (Tidal wave x Albino A+)” Cancel reply
You must be logged in to post a review.
Spores are illegal to possess in any form in the states of California, Georgia and Idaho. We don't ship our products to these states. The pictures posted to this website are for educational purposes only and are from environments outside of the USA.

Reviews
There are no reviews yet.